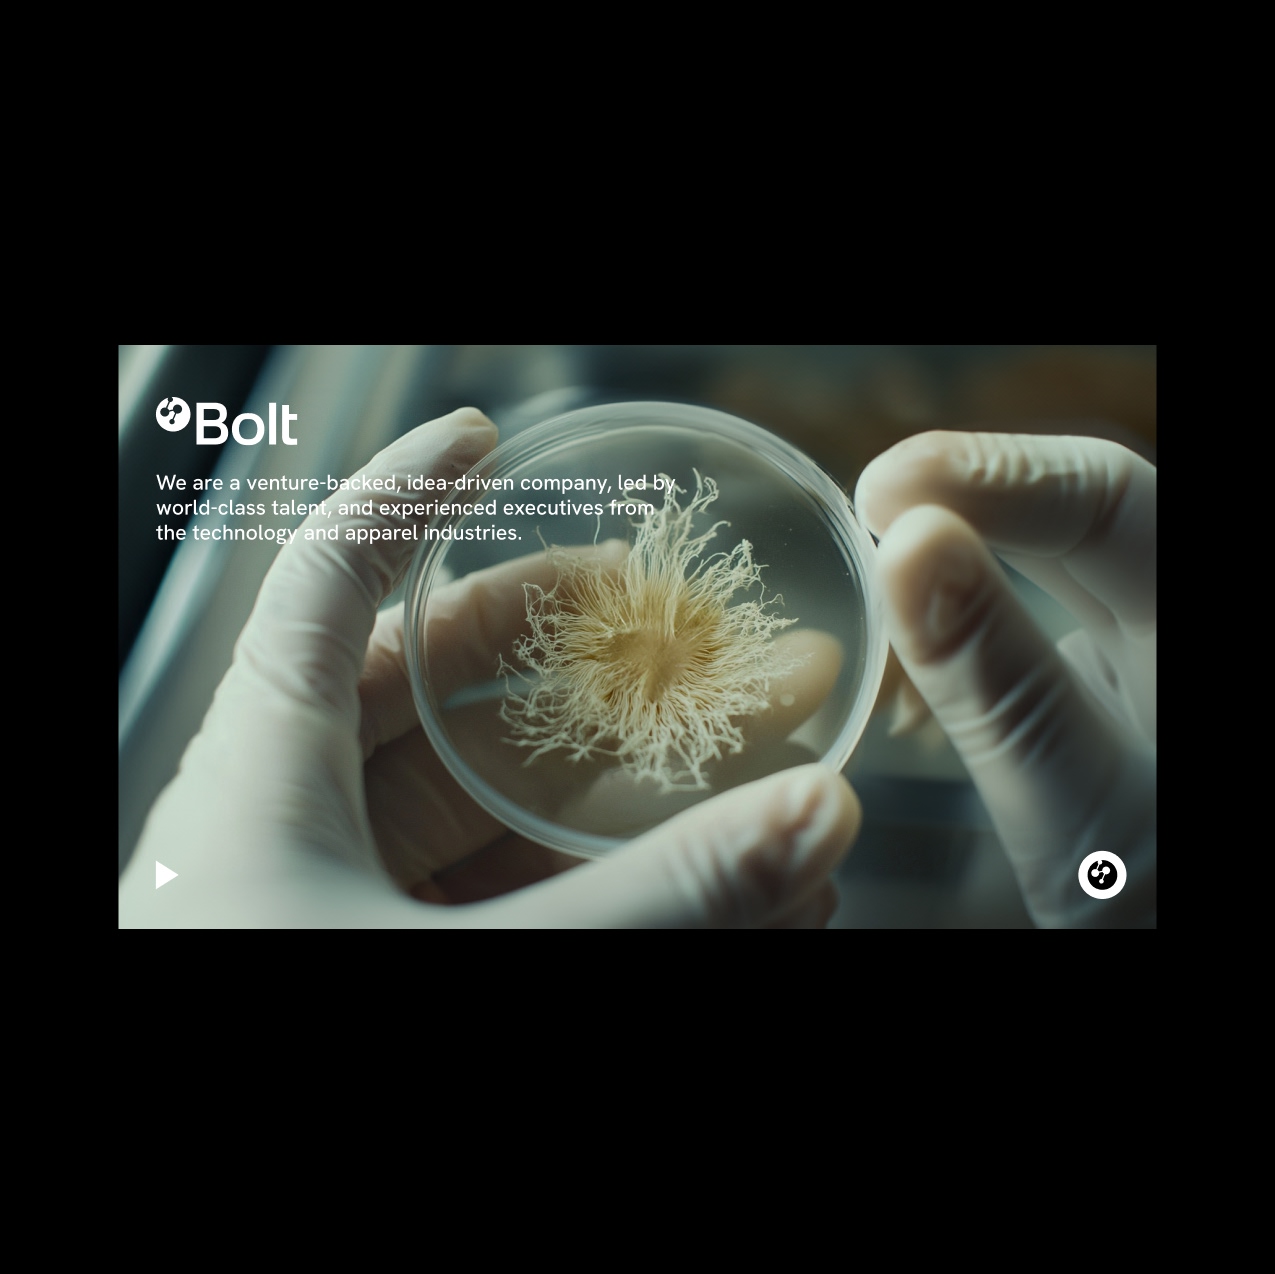

Bolt THreads - Thread Velocity
Inspired by Bolt’s vision of engineering the next generation of materials from nature, this project translates their innovation into a tactile visual language—where performance, sustainability, and material intelligence are felt, not just explained.

From Friction to Flow
Threading tools are typically presented as purely functional, catalog-style visuals, static angles, and technical overload.
This creates distance and fails to communicate speed, precision, and real-world efficiency.


A. Problem
The category relies on generic industrial imagery. Visuals lack hierarchy, motion, and context, making advanced tools feel interchangeable and uninspired.
B. Insight
Performance is understood through motion and clarity. When a tool feels fast, seamless, and exact, it communicates value instantly, before specs are even read.
C. Concept
A visual system built on sharp contrasts, directional lighting, and implied motion, where threads, cuts, and finishes emerge with precision from controlled environments, emphasizing speed, accuracy, and mechanical elegance.